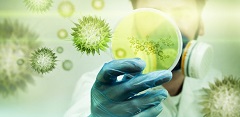

Trupi ynë, ashtu sikurse të gjitha organizmat e gjalla ka nevojë për energji që të egzistojë. Burimi i vetëm i energjisë, është glukoza. Glukoza është me rëndësi jetësore për organizmin. Pa të, qelizat e indeve, sidomos qelizat e trurit do të vdesin. Çdo formë tjetër e depozitimit të energjisë, siç janë lipidet, proteinat dhe llojet… Lexo të plotë